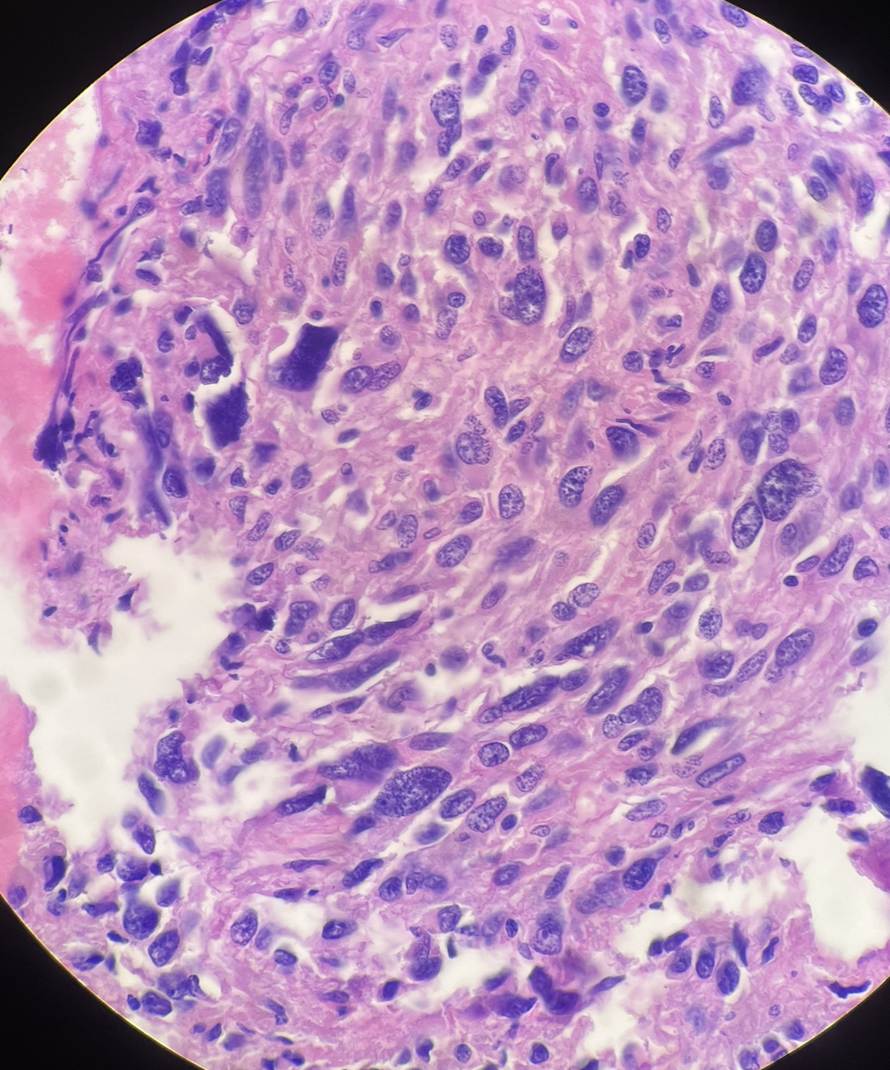

Cytology Support Services
Rapid On-Site Evaluation (ROSE) for Immediate Biopsy Adequacy
Precision. Speed. Confidence at the Point of Care.
Cyto Rose provides specialized Rapid On-Site Evaluation (ROSE) services for Fine Needle Aspiration (FNA) procedures — ensuring specimen adequacy in real time, reducing repeat biopsies, and improving diagnostic efficiency for hospitals, clinics, and interventional teams.
Procedure Status
Specimen Evaluation
Real-Time
Adequacy
↓ 90%
Repeat Biopsies
On-Site
Coverage
Cyto Rose cytology specialist confirms cellular adequacy before the patient leaves the procedure room.
Immediate Microscopic Evaluation at the Point of Care
Rapid On-Site Evaluation (ROSE) is a specialized service in which a cytology professional performs immediate microscopic evaluation during biopsy procedures. Our expert reviews each sample in real time — right in the procedure room — to confirm that adequate cellular material has been collected before the patient leaves. This eliminates unnecessary repeat procedures and accelerates the diagnostic pathway.
Supported Settings
- Interventional Radiology (IR)
- Endoscopy / EBUS
- Pulmonology
- Thyroid & ENT
- Oncology / Surgery
- Hospital Outpatient
- Ambulatory Centers
The Advantage
Why Cyto Rose?
We deliver precision cytology expertise where it matters most — at the procedure room, in real time, every time.
Immediate Adequacy Confirmation
Know right away if your specimen is diagnostic — before the needle is withdrawn.
Reduce Repeat Biopsies
Avoid unnecessary repeat procedures by confirming adequacy on the first pass.
Faster Turnaround Time
Real-time feedback shortens procedure time and accelerates the diagnostic workflow.
Experienced Cytology Specialist
Our specialists bring dedicated expertise in cytologic evaluation to every case.
Seamless Hospital Integration
We coordinate directly with your team and integrate smoothly into existing protocols.
Cost-Effective Solution
Reduce procedural waste and resource utilization with targeted on-site support.
Our Services
Comprehensive ROSE Support
From real-time specimen evaluation to flexible coverage models — every service is designed to integrate seamlessly into your workflow.
Rapid On-Site Evaluation (ROSE)
Real-time cytologic assessment during FNA procedures to confirm specimen adequacy before the patient leaves the room.
Specimen Preparation & Optimization
Expert smear preparation, cell block triage, and slide quality assurance to maximize diagnostic yield.
Procedure Room Support
Direct, real-time collaboration with your interventional team to guide sampling and optimize outcomes.
Flexible Coverage Models
Customizable service arrangements designed to fit your facility's volume and budget requirements.
Who We Serve
Built for Every Clinical Setting
Cyto Rose partners with a wide range of healthcare organizations that rely on accurate, timely cytologic evaluation.
- Hospitals
- Pathology Groups
- IR Centers
- Pulmonary & EBUS Programs
- Thyroid Biopsy Clinics
- Ambulatory Surgical Centers
The Cyto Rose Advantage
Designed to Elevate Every Procedure
By embedding expert cytologic assessment directly into the procedure workflow, Cyto Rose creates measurable improvements across clinical, operational, and patient experience dimensions — from the first needle pass to final diagnosis.
Proven Clinical Outcomes
- Improve biopsy success rates
- Reduce repeat procedures
- Optimize procedure time
- Enhance patient experience
- Support faster clinical decisions
About
Exclusively Dedicated to ROSE
Cyto Rose is dedicated exclusively to Rapid On-Site Evaluation (ROSE) — delivering precision cytology support at the point of care. Our mission is to improve diagnostic quality, procedural efficiency, and patient outcomes through reliable, real-time cytologic expertise.
100%
ROSE-Focused
Real-Time
Specimen Feedback
On-Site
Specialist Presence
Flexible
Coverage Models
Our Work
Cytology Under the Microscope
A selection of cytological preparations evaluated by our team — illustrating the diagnostic precision that ROSE brings to every procedure.

Ready to Add ROSE to Your Program?
Contact Cyto Rose today to discuss coverage options for your facility.
Contact
Get in Touch
Ready to discuss coverage for your facility? Reach out and a Cyto Rose specialist will respond within 1 business day.
Contact Information
Address
195 Montague St, Brooklyn, NY 11201
Email
your@email.com
Phone
(000) 000-0000
Website
www.CytoRose.com